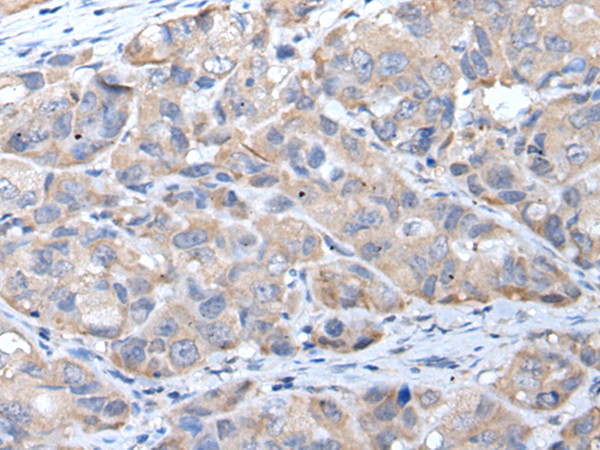

Background:
This gene encodes a muscle-specific class III intermediate filament. Homopolymers of this protein form a stable intracytoplasmic filamentous network connecting myofibrils to each other and to the plasma membrane. Mutations in this gene are associated with desmin-related myopathy, a familial cardiac and skeletal myopathy (CSM), and with distal myopathies.
Applications:
ELISA, WB, IHC
Name of antibody:
DES
Immunogen:
Synthetic peptide of human DES
Full name:
desmin
Synonyms:
CSM1; CSM2; LGMD2R
SwissProt:
P17661
ELISA Recommended dilution:
5000-10000
IHC positive control:
Human breast cancer
IHC Recommend dilution:
25-100
WB Predicted band size:
54 kDa
WB Positive control:
Jurkat and Hela cell
WB Recommended dilution:
200-1000

購物車
購物車 幫助
幫助
 021-54845833/15800441009
021-54845833/15800441009
